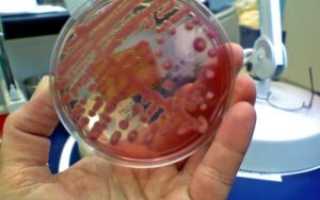
Дискомфорт в уретре. Клебсиелла пневмония

Клебсиелла пневмония в уретре у мужчин — признаки и лечение, причины и диагностика, способы, средства

Что такое клебсиелла?
Клебсиелла – условно-патогенная бактерия. Присутствует в микрофлоре здорового человека, однако при малом количестве клебсиеллы не вызывают инфекции.
Клебсиелла — неподвижный микроорганизм, может выживать без воздуха. Спор не образуют, но имеют способность создавать вокруг себя капсулу – непроницаемую оболочку, которая защищает бактерию практически от любого внешнего воздействия. Именно поэтому клебсиелла обладает высокой выживаемостью в любых условиях:
- в грунте,
- воде,
- на поверхностях предметов.
Заразиться клебсиеллой легко, уничтожить – не так просто. Погибают эти бактерии только при кипячении в течении 20-30 минут.
Есть минимум 7 разновидностей бактерии, которые живут в разных частях тела, но самой распространенной является клебсиелла пневмонии. При этом воспаление легких она вызывает достаточно редко, поскольку основное место ее обитания – желудочно-кишечный тракт. Если под влиянием различных причин клебсиеллы пневмонии начинают активно размножаться, и у человека развивается клебсиеллез.
Также инфекция может развиться при попадании бактерий на слизистую оболочку мочеполовой системы, дыхательных путей или на поверхность раны.
Биологические свойства
Во время исследований было выявлено, что бактерия легко окрашивается анилиновыми красителями. Она имеет небольшой размер, внешне напоминает коккобациллу. Микроорганизм может существовать в одиночестве, но чаще несколько сотен бактерий обнаруживаются в одном месте.
Бактерия неподвижна и не образует спор, но способна формировать капсулу. При помещении клебсиеллы на питательную среду из агар-агара отмечается образование колоний округлой формы и сероватого цвета. Они слизистые и небольшие. При попадании в среды с содержанием лактозы отмечается их сбраживание, которое обеспечивает именно палочка Фридлендера.
Чем опасна бактерия?
Клебсиеллез – инфекционная болезнь, которая характеризуется поражением ЖКТ, протекает чаще в виде острого гастроэнтерита или воспаления других органов, может даже вызвать сепсис.
Бактерии рода Клебсиелла не только вызывают тяжелые расстройства здоровья, но и имеют способность развивать устойчивость к антибиотикам (резистентность). Поэтому лечение клебсиеллеза – сложный и длительный процесс.
Группа риска по клебсиеллезу
Как уже говорилось, небольшое количество клебсиелл организм здорового человека в состоянии контролировать сам. Клебсиеллез же развивается чаще всего на фоне ослабленного иммунитета.
В группе риска:
- грудные дети;
- пожилые люди;
- пациенты с иммунными проблемами;
- люди, принимающие антибиотики широкого спектра действий.
- пациенты с заболеваниями ЖКТ;
- аллергики;
- имеющие хронические инфекции дыхательной системы;
- больные, принимающие лекарства, угнетающие иммунную систему (например, при лечении аутоиммунных заболеваний).
В пределах этой группы клебсиеллез чаще всего диагностируется у детей до года, поскольку их иммунная система несовершенна и при малейших сложностях не способна дать отпор активному размножению клебсиелл.
Впрочем, если в анализе кала новорожденного малыша обнаружили клебсиеллу, паниковать не стоит.
ВАЖНО! Как уже говорилось, клебсиелла – условно-патогенная бактерия, то есть она может стать причиной патологии только при определенных обстоятельствах. Поэтому полностью списывать на клебсиеллу колики, проблемы со стулом, вздутие живота точно не стоит.
4 самые распространенные детские инфекции и их симптомы
Клебсиолла в период новорожденности
Течение заболевания у детей особенно тяжелое. Часто выявляют возбудителя в моче. Необходимо трехкратное исследование и выяснение причин обнаружения в моче этих микроорганизмов.
У новорожденных детей данная инфекция встречается довольно часто. Проявляется дисбактериоз, который возникает, когда бактерия чрезмерно размножается в кишечных отделах ЖКТ малыша. Если у новорожденных выявляются симптомы диспепсии, то необходим анализ испражнений. Согласно этим исследованиям назначается лечение.
Клебсиеллез у беременных
Может ли ребенок внутриутробно заразиться от матери? Да, это возможно. Заражению малыша всегда предшествуют какие-либо экстрагенитальные инфекции или скрытые ее очаги, генитальные заболевания у матери.
- Инфицирование плода возможно через кровь или плаценту.
- Также заразиться ребенок от матери может восходящим путем: гениталии – влагалище – цервикальный канал – околоплодная оболочка – плод.
- Инфицирование может произойти также через околоплодные воды, когда инфекция проникает в организм неродившегося малыша через слизистые, пупочный канатик, ЖКТ, уши или глаза.
- Контактное инфицирование ребенка возникает во время процесса родов, когда он проходит через родовые пути.
Внутриутробное инфицирование клебсиеллой пороков развития плода не вызывает, но у ребенка может развиться сепсис, пневмония, отит, омфалит, конъюнктивит.
При клебсиеллезе у беременных регистрируется высокий уровень невынашивания беременности и мертворождаемости.
К группе риска по клебсиеллезу относят беременных, имеющих:
- маловодие или многоводие;
- плацентарную недостаточность;
- хориоамнионит;
- синдром задержки развития плода;
- преждевременное излитие околоплодных вод;
- бактериальный вагинит.
Также в группу риска включают беременных, в анамнезе которых:
- искусственное прерывание беременности;
- бесплодие;
- привычное невынашивание;
- преждевременные роды.
Итоги
Клебсиелла – бактерия условно-патогенной части микробиоты кишечника. При полноценной работе иммунной системы болезнетворный микроорганизм находится в мизерной концентрации и не представляет опасности.
У человека со сниженным иммунным статусом клебсиеллозная инфекция развивается в легких, кишечнике, мочеполовой системе, вследствие заражения от носителя бактерии или при употреблении инфицированных продуктов.
Определение патогена в моче проводится посредством бактериологического посева. Отклонением то нормы является показатель более 1000 КОЕ/мл.
Инфицирование беременной женщины угрожает ребенку патологиями внутриутробного развития. Клебсиелла в моче провоцирует развитие пиелонефрита, цистита, уретрита и других урологических заболеваний.
Терапия включает антибиотики, бактериофаги, витаминные комплексы.
Пути передачи инфекции
Наиболее распространенные пути передачи клебиеллы:
- воздушно-капельный (особенно интенсивный, когда больной человек кашляет или чихает);
- фекально-оральный (зараженный клебсиеллами кал попадает в грунт, оттуда – на овощи и фрукты, в питьевую воду).
Зафиксированы случаи, когда клебсиелла попадала в организм малыша при грудном вскармливании – при недостаточно тщательном уходе за сосками и в целом низкой гигиеной матери.
Носителем и передатчиком клебсиеллы всегда является человек.
Что такое TORCH-инфекции и чем они опасны для плода
Этиология явления
Основные причины инфекции: человек-носитель бактерий и собственные микроорганизмы, находящиеся в латентном состоянии.
Заражение чаще всего происходит при нарушении элементарных гигиенических правил: через загрязненные руки, немытые плоды, зараженные продукты (молочные и мясные изделия).
Инфицирование может происходить и воздушно-капельным путем при близком общении с зараженным человеком (кашель, чихание).
Хорошо работающая иммунная система способна противостоять бактериям. Активизируется клебсиеллезная инфекция при сбоях в работе иммунитета. Данное явление могут провоцировать такие причины:
Клебсиелла пневмония: пути заражения и описание бактерии, признаки и опасность заболевания, методы лечения у взрослых и детей

В обычных условиях Klebsiella Pneumoniae находится в кишечнике человека и не причиняет какого-либо дискомфорта. Это условно-патогенный микроорганизм.
Появление Клебсиеллы Пневмония в моче человека является следствием существенного ослабления иммунитета человека и может свидетельствовать о серьезных заболеваниях.
Чтобы успешно начать лечение вызванного бактерией заболевания, важно провести диагностику, опираясь на симптомы и результаты исследований.
О klebsiella pneumoniae
Klebsiella pneumoniae принадлежит к семейству Enterobacteriaceae. Она является грамотрицательной палочкой, живущей и развивающейся в условиях полного отсутствия воздуха.
При этом кислород не является для нее губительным (факультативный анаэроб). Клебсиелла покрыта оболочкой, что дает ей повышенную устойчивость к негативному воздействию окружающей среды.
В обычных условиях средой ее обитания является слизистая кишечника, где она не доставляет никаких проблем. Ее количество в моче здорового человека не должно превышать 105 КОЕ/мл.
Заражение чаще всего происходит в условиях стационара и при нарушении правил гигиены.
Пути заражения
В норме моча человека должна быть стерильной. Это значит, что при бакпосеве не должно вырастать никаких колоний микроорганизмов.
Однако существует множество патологических процессов, в результате которых эта стерильность нарушается.
Бактерия, обнаруженная в моче человека, попасть туда может несколькими путями:
- Очень часто Клебсиелла Пневмония передается воздушно-капельным путем.
- Бактерии из ЖКТ попадают в дыхательные пути во время рвоты.
- Фекально-оральный путь — через немытые фрукты, овощи и или из некачественных молочных продуктов.
В дальнейшем происходит активное размножение бактерии и распространение ее по всему организму.
Опасность клебсиеллы
При нарушении иммунитета есть риск активного размножения Клебсиеллы Пневмония в кишечнике человека. При этом начинают выделяться токсины, отравляющие организм человека.
Очень часто такое наблюдается после приема антибиотиков, когда естественная среда кишечника оказывается нарушается, и ее функции угнетаются из-за приема лекарств. В результате наблюдается поражение слизистой ЖКТ, развитие гастрита.
Кроме этого, заражение клебсиеллой может вызвать клебсиеллезную пневмонию.
При попадании бактерии в кровоток возможно развитие сепсиса и менингита. Эти заболевания смертельно опасны и требуют незамедлительного лечения.
Клебсиелла также может вызвать поражение мочеполовой системы. При попадании бактерии в мочевой пузырь может развиться цистит.
В группу риска заражения Клебсиеллой Пневмония входят следующие категории людей:
- Новорожденные и дети до года. В таком раннем возрасте еще нет полноценно сформированного иммунитета, поэтому инфицирование бактерией может спровоцировать серьезные последствия.
- Люди пожилого возраста. С возрастом защитные силы организма ослабевают, и он становится уязвимым для поражения многими болезнетворными бактериями.
- Беременные женщины.
- Люди, страдающие такими вредными привычками, как курение, чрезмерное употребление алкоголя. У них наблюдается патологическое изменение микрофлоры кишечника, что делает ее подверженной заражению Клебсиеллой.
Несмотря на то что Клебсиелла Пневмония является условно-патогенным микроорганизмом, заражение данной бактерией может крайне негативно сказаться на здоровье человека.
Именно поэтому важно, опираясь на признаки заболевания, своевременно направить пациента на диагностику и выявить возбудителя.
Признаки клебсиеллеза
Клебсиелла Пневмония, начав активно размножаться в организме человека, выделяет эндотоксин полисахаридной природы. Он образуется в случае разрушения защитной оболочки бактерии.
Если его концентрация велика, развивается инфекционно-токсическая реакция организма. При этом можно наблюдать признаки общей интоксикации.
Кроме этого, происходит выделение энтеротоксина, являющегося термостабильным. При его накоплении нарушается работа ЖКТ. Следует отметить еще мембранотоксин, оказывающий гемолитическое воздействие, а также разрушающий клеточную мембрану.
Если klebsiella pneumoniae обнаружена в моче, то можно предположить распространение инфекции по мочеполовой системе. При этом возможно развитие таких заболеваний, как:
- пиелонефрит;
- цистит;
- уретрит;
- кольпит.
Из основных признаков клебсиеллезной инфекции мочеполовых путей следует отметить:
- жжение и боль при мочеиспускании;
- болезненные ощущения в районе поясницы.
После поражения мочеполовой системы токсины начинают распространяться по всем организму, вызывая поражение других систем и органов.
Попадая в ткани легких, Клебсиелла Пневмония может вызвать опаснейшее заболевание, способное привести к смерти пациента. При этом наблюдаются следующие симптомы:
- одышка;
- кашель с мокротой, имеющей неприятный запах;
- усиление потоотделения;
- повышение температуры тела;
- озноб;
- прочие признаки общей интоксикации организма.
Не меньший вред бактерия вызывает, попадая в пищеварительную систему. Она провоцирует воспалительные процессы в слизистой ЖКТ (наиболее распространены гастрит и энтероколит). Из симптомов следует отметить:
- боль в желудке или в животе;
- тошнота и рвота;
- изжога;
- частый стул;
- слабость.
Особенно опасна клебсиелла, обнаруженная в моче у ребенка. Образующиеся эндотоксины способны вызвать сепсис или токсический шок.
Мишенью сепсиса могут быть разные органы: печень, почки, головной мозг и прочие. У детей в возрасте до года поражение клебсиеллой чаще всего напоминает симптомы дисбактериоза.
У ребенка наблюдаются:
- колики;
- частые срыгивания;
- нестабильность стула;
- метеоризм.
Длительная диарея к общему состоянию интоксикации добавляет еще и обезвоживание. В таких случаях необходима срочная госпитализация.
Обнаружение Клебсиеллы Пневмония в анализе мочи у мужчин и женщин, и особенно у детей требует незамедлительного лечения.
Методы диагностики
Диагностировать инфицирование клебсиеллой достаточно трудно. Сходная симптоматика характерна и для многих других заболеваний. Именно поэтому в данном случае недостаточно обычного осмотра врачом. Требуется дополнительная лабораторная диагностика.
К основным исследованиям относятся:
- Бактериоскопия — изучение под микроскопом образцов крови и мочи.
- Бактериологическое исследование. Наиболее эффективное и доступное. Заключается в посеве мочи на питательную среду, оптимальную для развития клебсиеллы. Результат положительный, если через 20-25 часов будут обнаружены колонии характерного голубовато-металлического или зелено-голубого цвета.
- Серологический способ. Используется редко, в качестве уточняющего метода.
При необходимости применяют другие инструментальные диагностические методы, позволяющие уточнить диагноз.
Способы лечения
Для того чтобы эффективно лечить Клебсиеллу Пневмония, обнаруженную в моче человека, важно принимать во внимание клиническую картину в целом, возраст пациента и индивидуальные особенности организма.
Пациент может лечиться как в домашних условиях, так и в стационаре. Все зависит от тяжести заболевания и степени интоксикации организма.
Лечение маленьких детей в большинстве случаев проводится в больнице из-за высокого риска осложнений.
Чаще всего назначают комплексную терапию. Она включает следующие группы лекарственных средств:
Они входят в базовое лечение, и их действие направлено на подавление размножения и уничтожение самих бактерий. Чаще всего назначают тетрациклины и цефалоспорины 3 и выше поколений.
Неплохой результат дают аминогликозиды последнего поколения, и полусинтетические антибиотики пенициллинового ряда. В редких случаях возможно назначение фторхинолонов.
Антибиотики назначают с учетом индивидуальной непереносимости. В идеале следует провести тест на чувствительность конкретной бактерии к разным группам антибиотиков. Для усиления эффекта возможно использование нескольких препаратов.
Данные лекарственные средства изготавливают на основе вирусных частиц, способных блокировать активность клебсиеллы. Чаще всего выпускаются в виде раствора для приема внутрь.
Их роль — восстановление нормальной микрофлоры, пострадавшей как от возбудителя заболевания, так и от лекарственной терапии.
Все лекарственные средства, назначаемые для лечения клебсиеллеза, делятся на 3 группы:
- этиотропные (антибактериальные средства);
- патогенетические (снижают риск осложнений);
- посиндромальные (купируют проявления заболевания).
- Немалую пользу могут принести и народные методы лечения, но их следует использовать как дополнение к основному лечению.
- Больному рекомендуют пить яблочные и клюквенные соки, отвары из тысячелистника и осиновой коры, подорожника и ромашки.
- Естественно, важно не забывать и о профилактике заболевания.
- Наличие палочки клебсиеллы в мочеполовых путях человека может привести к заболеваниям, приводящим к интоксикации организма и поражению многих органов.
- Поэтому, почувствовав неприятные ощущения при мочеиспускании, а также боль в пояснице, важно не заниматься самолечением, а обязательно обратиться к врачу.
- Квалифицированный специалист проведет диагностику, выявит причину недомогания и назначит соответствующее лечение.
Клебсиелла в моче
Наличие в анализе мочи клебсиеллы свидетельствует о том, что произошло заражение одного из участков организма. Бактерия при своей жизнедеятельности формирует патогенную среду, которая оказывает отрицательное влияние на состояние органов человека.
Чем опасна клебсиелла
По своей сути клебсиелла является бактерией, которая постоянно присутствует в организме, не представляя опасности. Однако существуют условия, при которых микроорганизм может нанести человеку вред.
В норме бактерия находится внутри кишечника, если ее обнаруживают в анализе мочи – это патология. Фото микроорганизма можно найти на медицинских порталах интернета. Специалисты выделяют несколько видов этих микробов.
Самыми распространенными у человека среди них являются:
- Klebsiella pneumaniae (палочка Фридлендера), вызывает патологии легких;
- Klebsiella oxytoca (Клебсиелла окситока), способствует развитию заболеваний кишечника.
Когда иммунная система человека угнетена или работает с недостаточной силой, бактерия начинает быстро размножаться, приводя к формированию заболеваний:
- пневмонии – при поражении органов дыхательной системы;
- пиелонефрита, простатита, цистита – при воздействии на половую и мочевыделительную систему;
- гастроэнтерита, колита, гастрита – во время размножения внутри органов ЖКТ.
Неконтролируемое развитие заболевания может привести к страшным последствиям: сепсису и летальному исходу. Помимо перечисленных систем, палочка часто поражает и другие части человеческого тела.
Клебсиеллез пагубно влияет на иммунитет, поэтому, переболев, человек снова может подвергнуться воздействию заболевания через некоторое время.
Причины возникновения инфекции
Разносчиком инфекционного клебсиеллеза может стать зараженный им человек. Если недуг проявляется как пневмония, то передача происходит через воздух и жидкости, выделяемые при кашле или чихании.
Заразиться можно при пренебрежении правилами гигиены. В этом случае клебсиелла попадает внутрь кишечника.
Скушав немытую и необработанную пищу, человек увеличивает риск проникновения микроорганизма внутрь пищеварительного тракта.
Приобрести инфекцию может любая категория лиц, однако есть те, кто рискует особенно сильно в силу ослабленного состояния иммунитета:
- новорожденные дети и груднички;
- люди пожилого возраста;
- пациенты, имеющие хронические заболевания или имевшие операции по трансплантации органов;
- хронические алкоголики.
Клебсиелла в моче: лечение пневмонии klebsiella pneumoniae у взрослых

Клебсиелла в моче часто становится тревожным признаком серьезных патологий. Само ее присутствие в организме еще не говорит о развитии болезни, но вероятность ее развития в определенных условиях достаточно велика.
В связи с тем, что наличие такой инфекции не предвещает ничего хорошего, с ней необходимо бороться, не дожидаясь тяжелых последствий.
Современные средства позволяют обеспечить эффективное лечение, но важно его начать своевременно.
Сущность проблемы
Бактерия клебсиелла относится к микроорганизмам с условной патогенностью.
Другими словами, она очень часто присутствует в человеческом организме, ничем себя не проявляя, но способна начать свою патологическую миссию при появлении благоприятных условий, в частности при снижении иммунной защищенности.
Эта инфекция является грамотрицательным микроорганизмом из разряда энтеробактерий. Она обладает достаточно прочной наружной капсулой, которая обеспечивает ее высокую выживаемость в окружающей среде, в т. ч. при повышенной температуре и воздействии многих антибиотиков.
Один из самых распространенных вариантов выявления этой заразы в человеческом организме — клебсиелла пневмония (klebsiella pneumoniae в моче) указывает на присутствии такой разновидности бактерии в мочевыделительной системе (почках, мочевом пузыре, мочеточнике или мочевыводящем канале). Нередко в моче можно выявить еще один тип бактерии — клебсиелла окситока. Надо отметить, что инфекция поражает людей обоих полов, причем фиксируется как у взрослых, так и у детей разного возраста.
Наличие такого микроорганизма, как клебсиелла пневмония в моче, в принципе, нельзя расценивать как патологию. Она очень часто входит в состав естественной микрофлоры мочевыводящей системы.
Установлено, что физиологическая норма присутствия таких видов, как пневмония и окситока, в моче достигает 90000–105000 колониеобразующих единиц (КОЕ) на 1 мл.
Повышение этого уровня указывает на развитие урологических проблем, а значит, требуется лечение.
Симптоматика активизации бактерий
- Оккупировав человеческий организм, клебсиелла выделяет агрессивный эндотоксин — липополисахарид, возникающий при разрушении капсулы бактерии.
- При достаточной концентрации его провоцируется реакция инфекционно-токсического типа, характеризующаяся общей интоксикацией организма.
- Кроме того, выделяется термостабильный энтеротоксин, ведущий к нарушению системы пищеварения, и мембранотоксин, проявляющий гомолитические способности и разрушающий клеточные ткани.
Если клебсиеллу обнаружили в анализе моче, то, прежде всего, можно предположить развитие патологий мочевыделительной системы: пиелонефрит, цистит, уретрит, кольпит. Инфекция вызывает достаточно активный воспалительный процесс с такими проявлениями, как жжение и болезненность при мочеиспускании, болевой синдром в области поясницы.
Помимо прямого поражения мочеполовой системы, токсины распространяются по всему организму, вызывая нарушения в различных внутренних органах. Одним из самых опасных проявлений считается особый тип пневмонии, провоцируемый klebsiella pheumonial.
Она встречается достаточно редко, но развивается стремительно и может привести к трагическим последствиям.
Чаще возбуждается легочная воспалительная реакция, выражающаяся такими симптомами, как одышка, кашель с мокротой и неприятным запахом, повышенное потоотделение, подъем температуры тела, озноб, признаки общей интоксикации организма.
Попадая в ЖКТ, клебсиелла способна вызвать серьезные нарушения воспалительного характера. Воспаление желудочной слизистой оболочки (гастрит) характеризуется болевым синдромом в районе желудка, тошнотой и рвотой, изжогой, ухудшением аппетита и похудением.
При поражении кишечника может провоцироваться энтерит или энтероколит острого типа. В этом случае выявлена такая симптоматика: болевые схваткообразные приступы в области живота, диарея с кровяными примесями, тошнота, общая слабость.
Острые проявления могут отмечаться в течение 3–4 суток.
В младенческом возрасте наиболее выраженными симптомами клебсиеллозного поражения считаются признаки, напоминающие проявление дисбактериоза, а именно колики, нестабильность стула, учащенное срыгивание, метеоризм. Наиболее характерно появление длительной диареи, что угрожает обезвоживанием детского организма.
При таком условии очень вероятны рецидивы инфицирования.
Диагностические мероприятия
Поставить предварительный диагноз клебсиеллозной инфекции очень сложно, в связи с тем что проявляются симптомы, характерные для пораженных органов, а конкретный тип возбудителя может быть выявлен только по результатам лабораторных и инструментальных исследований. В качестве материала используется анализ мочи, крови, мокроты, слизи и т. д.
Для постановки точного диагноза используются следующие диагностические методы:
- Бактериоскопия. Основана на микроскопировании образцов, когда выявляются бактериальные палочки. Определяется вариант их группирования: единичные бактерии, пары или цепочки.
- Бактериологиеский способ. Считается основной методикой диагностики. Он реализуется в виде посева анализа на питательную среду для оценки роста бактериальных колоний. Уже через 20–25 часов обнаруживаются соответствующие колонии, имеющие голубовато-металлический или желтовато-зеленоватый оттенок.
- Серологический способ. Применяется достаточно редко в качестве уточняющего исследования. Такому методу обычно подвергается кровь больного человека для выявления роста титра антител.
- В качестве дополнительных методов применяются инструментальные технологии для уточнения течения осложнений и степени поражения соответствующего органа.
Принципы лечения
Лечение клебсиеллозной инфекции осуществляется с учетом клинической картины, возрастного фактора, особенностей организма, индивидуальной реакции организма на медикаментозные препараты. Терапия может производиться в домашних условиях или путем госпитализации. Последний вариант рекомендуется для маленьких детей и при тяжелом течении патологии.
Лечение обеспечивается по комплексной схеме с назначением таких групп препаратов:
- Антибиотики. С их помощью обеспечивается базовое лечение, т. е. прямое воздействие на возбудителей инфекции. Наиболее часто назначаются тетрациклины, цефалоспорины (третьего и четвертого поколения), аминогликозиды (последнего поколения), пенициллины полусинтетического типа. Иногда используются препараты группы фторхинолонов. Антибиотики подбираются с учетом индивидуальной восприимчивости. Для повышения эффективности данных средств могут составляться комбинации из них.
- Бактериофаги. Такие препараты готовятся на основе вирусных частиц, способных блокировать активность рассматриваемых микроорганизмов и замедлить развитие колоний. Как правило, они принимаются внутрь в форме раствора. Находят применение такие средства, как Бактериофаг клебсиелл пневмонии, Пиобактериофаг поливалентный очищенный жидкий, Бактериофаг клебсиелл поливалентный. Наибольшей популярностью пользуются препараты Экофлор, Энтерол, Бифидум, Трилакт.
- Пробиотики. Такие средства необходимы для восстановления микрофлоры, нарушенной приемом антибиотиков. В зависимости от типа основной терапии выбор делается из таких препаратов: Бифидумбактерин, Пробифор, Аципол, Ацилакт, Бифиформ, Линнекс, Биовестин, Бифилонг, Нормофлорин, Примадофилюкс.
Дополнительное лечение подразумевает симптоматическую терапию, в частности, нередко приходится использовать такие виды, как:
- этиотропная терапия с применением антибактериальных средств;
- патогенетическая терапия для устранения осложнений;
- посиндромальная терапия.
Народные средства
Любое лечение патологий кишечника следует согласовывать со специалистом, при этом народные средства должны использоваться лишь как дополнение к основной комплексной терапии. Необходимо включить в рацион яблочный и клюквенный соки.
К тому же, могут помочь отвары из тысячелистника, осиновой коры, сосновых/березовых почек. Рецепт несложный: 1 ст. л. сухой смеси заливается 1 стаканом кипятка. Средству нужно дать настояться несколько часов, затем разделить на 3 части и выпить за день.
Не нужно забывать о том, что нормализация микрофлоры невозможна, если кишечник забит патогенными микроорганизмами. По этой причине перед тем, как принимать пробиотики, нужно «очиститься» травяными настоями, имеющими фитонцидный эффект. Для этих целей подойдут подорожник или ромашка. Именно эти травы обладают фитонцидным действием. Употреблять отвары следует натощак.
К сожалению, медицина не имеет вакцины, способной победить клебсиеллу. В качестве профилактики можно рекомендовать:
- укрепление иммунитета;
- соблюдение элементарных норм гигиены;
- своевременное лечение инфекций и хронических болезней.
Клебсиелла, обнаруженная в моче, причем в количествах, превышающих норму, свидетельствует о наличии патологического инфекционного развития. Бактерия обладает высокой устойчивостью, но при правильном выборе лечебной схемы можно успешно бороться с болезнью, предотвращая рецидивы.
Клебсиелла в моче: лечение инфекции
Наличие в анализе мочи клебсиеллы свидетельствует о том, что произошло заражение одного из участков организма. Бактерия при своей жизнедеятельности формирует патогенную среду, которая оказывает отрицательное влияние на состояние органов человека.
По своей сути клебсиелла является бактерией, которая постоянно присутствует в организме, не представляя опасности. Однако существуют условия, при которых микроорганизм может нанести человеку вред.
Клебсиелла в моче: причины klebsiella pneumoniae у взрослых

Клебсиелла в моче часто становится тревожным признаком серьезных патологий. Само ее присутствие в организме еще не говорит о развитии болезни, но вероятность ее развития в определенных условиях достаточно велика.
В связи с тем, что наличие такой инфекции не предвещает ничего хорошего, с ней необходимо бороться, не дожидаясь тяжелых последствий.
Современные средства позволяют обеспечить эффективное лечение, но важно его начать своевременно.